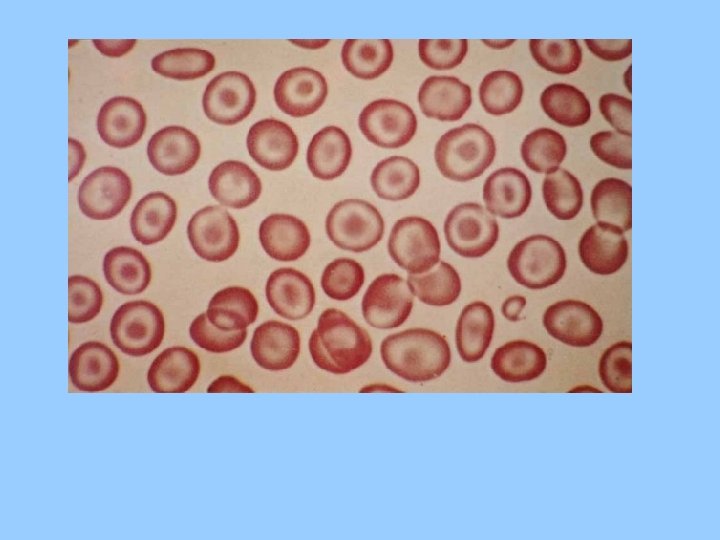

CASO CLNICO Anemia falciforme Apresentao Edilson Srgio de






































- Slides: 38

CASO CLÍNICO: Anemia falciforme Apresentação: Edilson Sérgio de Paula Jr. Eduardo Carvalho Coordenação: Luciana Sugai www. paulomargotto. com. br Brasília, 24 de fevereiro de 2012

• ID: DRC, 5 anos, sexo feminino, natural e procedente de Planaltina-GO. • QP: “Dor no peito e nas costas” há 2 dias.

• HDA: Criança refere dor torácica há 2 dias, associado a tosse produtiva esparsa e hiporexia. Procurou este serviço há 1 dia, foi medicada apenas com dimeticona para gases evidenciados em Rx feito no PS e recebeu alta. Como persistiu com o quadro de dor torácica, retornou a este serviço há 1 dia. Nega febre ou dispnéia. Sem outras queixas álgicas. Eliminações preservadas.

• Antecedentes Fisiológicos: Nasceu de parto normal, à termo, sem intercorrências neonatais. Não realizou teste do pezinho e orelhinha. Ao nascimento seu percentil na curva de peso x idade era adequado, porém aos 6 meses de vida sua curva tornou -se retificada, atingindo níveis abaixo de p 3 aos 10 meses de idade. DNPM adequado.

Antecedentes Patológicos: • Nega co-morbidades, cirurgias ou alergias medicamentosas. Relata diversas internações prévias por dor abdominal mal esclarecida e pneumonia (cerca de 4). • A última internação antes da atual ocorreu há aproximadamente 9 meses devido a episódio de PNM. Refere duas transfusões sangüíneas durante internações prévias.

• Antecedentes Familiares: Mãe (32 a) hipertensa há 1 ano em uso de Captopril; Pai (36 a) hígido; Tem 3 irmãos saudáveis. • Hábitos de Vida e Condições Socioeconômicas e Ambientais: Reside em casa de alvenaria, 4 cômodos, 6 pessoas, com saneamento básico. Nega animais ou tabagismo no domicilio.

Exame Físico • Ectoscopia: BEG, fácies de dor, hidratada, hipocorada (+++/+4), ictérica (++/+4), afebril (36, 3°C), hipoativa e reativa. • AR: MVF+ sem RA, ausência de esforço respiratório. FR: 40 ipm. Sat O 2 em ar ambiente: 92 - 93%. • ACV: RCR 2 T BNF sopro sistólico +++/+6 em foco mitral. FC: 140 bpm. • ABD: Flácido, indolor, um pouco distendido, RHA+, sem VMG. • EXT: bem perfundidas e sem edema. • NEURO: s/ sinais meníngeos.

HIPÓTESES DIAGNÓSTICAS

Exames • • • Na = 137 m. Eq/L K = 4, 4 m. Eq/L Cl = 100 m. Eq/L TGO = 44 U/L / TGP = 23 U/L Hemácias = 2, 91 milhões / Hb = 9, 0 g/d. L -/Ht = 24, 5% • Leucócitos = 16. 000 (57 S, 0 B, 0 E, 4 M, 38 L); • Plaquetas = 273. 000/u. L;

Exames • Contagem de Reticulócitos = 3, 0 % (VR=0, 5 - 1, 5) • Morfologia das Hemácias: Anisocitose (+) Drepanócitos(+) Hipocromia(++) • VHS = 32 mm/hora • BD: 0, 2 / BI: 2, 3


ANEMIA FALCIFORME

• Hemoglobinopatia genética estrutural • Doença autossômica recessiva caracterizada pela herança homozigótica da Hbs • Anemia hemolítica + oclusão vascular • Doença hematológica hereditária mais comum da humanidade • Mais de 4 milhões de portadores do gene da Hb. S; 25000 a 30000 pessoas possuem a doença no Brasil

Distribuição normal de hemoglobina no adulto Eletroforese de Hb: • Hb. A-α 2β 2 = 95 -98% • Hb. A 2 -α 2δ 2 = 1, 5 -3% • Hb. F-α 2γ 2 = 0 -1%

• Mutação de ponto (GAG->GTG) no gene da globina β da hemoglobina (substituição de um ácido glutâmico por uma valina na posição 6 da cadeia beta)= Hb. S. . Modificação fisicoquímica da molécula de Hb.


• Fenômenos vasoclusivos -adesão das hemácias no endotélio vascular -lentificação do fluxo sanguíneo -afoiçamento na microcirculação -oclusão do vaso

• Hemólise -extravascular -meia vida das hemácias do pct falcêmico: 20 dias -macrofagos esplênicos fagocitam precocemente essas hemácias devido: 1. Perda da elasticidade e deformabilidade 2. Opsonização por autoanticorpos Ig. G

Disfunção esplênica • Autoesplenectomia • Papel do baço na defesa imunológica • Principais infecções e agentes

Manifestações clínicas agudas -Sd. Mão-pé -Crise óssea -Crise abdominal -Crise hepática -Priapismo -AVE

Crises anêmicas • Sequestro esplênico -crise anêmica mais grave -obstrução aguda de sinusóides esplênicos, dificultando a drenagem venosa, causando aumento do órgão, hipovolemia e anemia graves -comum entre 6 meses e 1 ano de idade -esplenectomia recomendada após estabilização

• Anemia aplásica -crise anêmica mais comum -relacionada à infecção pelo parvovírus B 19 -queda abrupta do hematócrito e da contagem de reticulócitos -o quadro pode se iniciar c/ síndrome febril, evoluindo para anemia aguda grave -curso autolimitado (5 a 10 dias) -tratamento: hemotransfusão

Manifestações crônicas • • • Crescimento e desenvolvimento Ostearticular Renal Hepatobiliar Pulmonar Cardiovascular SCN Ocular Cutâneo

Diagnóstico Laboratorial • Anemia moderada (Hg 8, 0 g/dl e Hct 24%) • Índices hematimétricos normais (anemia normo) • Reticulócitos • Depranócitos (foices) • Hemácias em alvo • Corpúsculos de Howell-Jolly

• • • Leucocitose neutrofílica Trombocitose VHS Bilirrubina Indireta Eletroforese de Hemoglobina

Distribuição das hemoglobinas síndromes falciformes

Tratamento • Medidas Gerais: – Profilaxia:

– Ácido Fólico – Crises algicas: – – HV rigorosa Morfina Evitar hipoxemia TTO causa precipitante – Febre alta: TTO pneumococo com Ceftriaxona

• Transfusao: Objetiva reduzir o percentual de Hb. S para níveis < 30%. Risco de hemocromatose (acumulo de ferro nos tecidos, que leva a cirrose hepatica, DM, cardiopatia. TTO: deferoxamina). • Indicacao de transfuao aguda: – Crise anêmica – Crise álgica refratária – Hematuria prolongada – Pré operatório • Indicacao de transfusao crônica (10 ml/kg, a cada 3 -5 semanas. Visa Hg 12) – – – História de AVE Retinopatia grave Úlcera maleolar refrataria Doenca renal progressiva Alteração do Doppler transcraniano

• Exsanguineotransfusao – Fase aguda do AVE – Sindrome toracica grave – Priapismo refratário • Hidroxiureia: Agente mielossupressor que ativa a sintese de Hb. F. E reservado para adolescentes e adultos com episódios algicos frequentes. Pode causar leucopenia

Síndrome Torácica Aguda

• A fisiopatologia desta síndrome ainda é discutível. O papel de infecção pulmonar parece ser relevante, mas eventos embólicos pulmonares, muitas vezes na forma de embolia gordurosa talvez sejam o principal fator fisiopatológico.

Critérios Diagnósticos • Presença de infiltrado novo em radiografia envolvendo pelo menos um segmento pulmonar completo (descartando atelectasia); • Dor torácica; • Temperatura > 38, 5°C; • Taquipnéia, tosse ou sibilância.

Exames • • • RX de tórax; Hemograma com contagem de reticulócitos; Hemocultura, BAAR e cultura de escarro (se possível); Gasometria arterial em ar ambiente; Títulos para Mycoplasma pneumoniae (agudo e evolutivo se possível); • Cintilografia cardíaca – mapeamento cardíaco – está indicado quando existem sintomas torácicos com RX de tórax normal; • ECG (opcional); • Estudos virais (opcional).

Manejo terapêutico • NÃO Hiperidratar: Deve ser instituída a hidratação parenteral nas necessidades hídricas diárias sem descontar a VO. • O 2 se Pa. O 2 < 80% (gasometria arterial) • ATB IV: Ampicilina, Cefuroxima ou Ceftriaxona (deve ser iniciada imediatamente) *se suspeitar de Mycoplasma pneumoniae: macrolídeo • Se houver derrame pleural Rx: Toracocentese • Exsanguíneotranfusao

• OBRIGADO! Ddo Edilson Ddo Eduardo